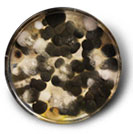

È importante sapere che la pollinazione delle piante avviene durante tutto l’anno, anche se tra Marzo e Maggio la concentrazione dei pollini può essere molto alta. Conoscere le piante alle quali si è allergici e anche il ciclo di vita della pianta stessa è quindi utile per capire i mesi più a rischio.
Leggi le schede su alcune delle piante che possono causare allergia e scopri più sul polline e altri allergeni.

Carpino bianco e carpino nero:
Diffusione:
Prevalentemente nei boschi misti nelle regioni alpine e lungo l'Appennino.
Descrizione:
Alberi decidui che possono crescere fino a 12-20 m.
Hanno foglie ovali, alterne e appuntite, con margine doppiamente dentato, nervature parallele e pubescenti.
I fiori unisessuali sono amentiformi, quelli maschili cilindrici e penduli, quelli femminili allungati, portati da una brattea acuminata e con stimmi rossi che sporgono dall'apice.
I frutti del carpino bianco sono acheni tondeggianti accompagnati da una brattea triloba con il lobo mediano molto allungato. Nel carpino nero gli acheni sono protetti da brattee erbacee sacciformi biancastre.
Fioritura:
Le due specie hanno periodi di fioritura molto vicini, il Carpino nero tra metà marzo e metà maggio, il Carpino bianco principalmente tra la fine di marzo e l'inizio di giugno.

Ambrosia:
Diffusione:
L'ambrosia è diffusa dal nord verso il centrosud.
Le piante appartenenti a questo genere sono erbe infestanti che crescono in prati asciutti e soleggiati, lungo gli argini dei fiumi, sui margini delle strade e in genere nei terreni abbandonati.
Le specie più diffuse in Italia sono:
A. maritima L., presente lungo i litorali sabbiosi.
A. artemisiifolia L. (=A. elatior).
A. trifida, e più sporadicamente.
A. coronopifolia Torr. et Gray (=A. psilostachya)
Descrizione:
L'Ambrosia è una pianta annuale o perenne che può raggiungere l'altezza di 150cm; forma cespugli che crescono in folti gruppi.
Le foglie pennatosette, di colore verde più o meno scuro, presentano spesso una fitta peluria argentea.
L'ambrosia è una pianta monoica, cioè produce fiori maschili e femminili separati, ma nello stesso individuo. I fiori unisessuali sono riuniti in piccoli capolini, quelli femminili dall'ascella delle foglie più alte, quelli maschili riuniti in grandi racemi terminali.
Il frutto è costituito da acheni spinosetti. Ogni pianta produce grandi quantità di polline e moltissimi semi.
Fioritura:
La fioritura inizia in agosto e si prolunga fino ad ottobre.

Ontano:
Diffusione:
Comunemente diffuso nell'emisfero boreale.
Molto usato nel rimboschimento dei terreni argillosi e sassosi, e per il consolidamento delle frane.
Le radici dell'ontano formano associazioni simbiotiche con batteri che fissano azoto (genere Frankia), pertanto vengono piantati in terreni poveri per arricchirli di questo elemento.
Descrizione:
Al genere Alnus appartengono diverse specie. Si tratta di alberi che crescono lungo i corsi d'acqua, in luoghi freschi e umidi possono raggiungere l'altezza di 25m.
L'ontano nero è quello più comunemente presente. E' un albero a foglie decidue, semplici, alterne, obovato-ellittiche arrotondate e con apice smarginato.
Alnus incana (Ontano bianco) e Alnus viridis (O. verde) diffusi al nord, hanno foglie ad apice acuto e base cuneata.
Alnus cordato (ontano napoletano) presenta foglie a base cuoriforme e apice acuto ed è diffuso nel meridione. I fiori unisessuali crescono sulla stessa pianta, quelli maschili riuniti in amenti lunghi da 5 a 15cm, pendenti e di colore giallo-bruno, quelli femminili, riuniti in brevi infiorescenze ovali, significate, erette, spuntano in primavera.
Fioritura:
La fioritura ha luogo tra fine inverno e aprile.

Cipresso:
Diffusione:
Il cipresso è una specie presente in Italia fin dai tempi degli etruschi, ma originaria dei paesi mediterranei orientali.
Diffuso soprattutto nelle regioni dell'Italia settentrionale e centrale, è una specie che si adatta a vivere anche su terreni molto poveri, in zone calde con estate siccitosa, in Italia si trova dal mare a circa 700 metri.
Il suo legno è utilizzato per lavori di ebanisteria e per la costruzione di mobili, poichè si dice che il suo odore aromatico tenga lontano le tarme.
Molto diffusi perchè coltivati
C. arizonica
C. macrocarpa
C. Chamaecyparis lawsoniana
Junipers communis
Calocedrus
Descrizione:
Albero ad accrescimento lento, molto longevo, ha un portamento slanciato, colonnare, ramificato fino alla base, che può raggiungere i 30 m di altezza.
Le foglie sono squamiformi e appiattite, appressate ai rami ed embricate fra loro, di colore verde cupo.
I fiori maschili sono disposti in strobili giallastri all'estremità dei rametti; quelli femminili in strobili globosi, chiamati galbuli, che a maturità lignificano. Le squame si aprono per poi lasciare cadere semi piccoli e rossicci.
Fioritura:
Il periodo di presenza del polline di cipresso nell’aria è compreso tra febbraio e maggio.

Betulla:
Diffusione:
La betulla è distribuita nell'emisfero boreale tra il 30° e il 72° parallelo, dalla Scandinavia settentrionale fino all'Etna. In Italia la sua presenza naturale è più comune sulle Alpi, nelle radure e nelle pinete, divenendo sporadica sull'Appennino settentrionale, assente in quello centrale e nuovamente presente in maniera puntiforme in quello campano per riapparire a circa 2700m sull'Etna. Viene invece comunemente introdotta nei parchi e nei giardini cittadini.
Descrizione:
Specie eliofila, la betulla è un albero a foglie decidue che cresce fino a 30m, preferibilmente su terreni acidi, poveri o sabbiosi umidi.
Il fusto, dal caratteristico colore bianco cresce sinuoso. La corteccia presenta lunghe lenticelle nere.
Le foglie sono semplici, alterne lungamente spicciolate, ovato-deltate con apice acuto e lamina dentellata.
I fiori sono unisessuali: quelli maschili, riuniti in amenti pendenti, sono di colore giallo-verdi, lunghi 3-6cm; quelli femminili, riuniti in amenti eretti, hanno un colore verde e sono lunghi fino a 3cm.
I frutti sono dei piccoli acheni alati, compressi.
Fioritura:
La fioritura avviene simultaneamente alla comparsa delle foglie tra la fine di marzo e l'inizio di maggio.

Nocciolo:
Diffusione:
Il nocciolo è largamente diffuso in tutta Italia come pianta spontanea nel bosco misto di caducifoglie; viene coltivato per il frutto, destinato al consumo fresco o secco, o usato nell'industria dolciaria.
Descrizione:
È un arbusto deciduo che cresce fino a 8 m di altezza, con numerosi rami paralleli e una larga chioma. Le foglie sono tormentose, alterne, di forma tondeggiante con base cordata e apice appuntito, il margine è doppiamente dentato, nervature molto prominenti nella pagina inferiore.
I fiori compaiono in dicembre, quelle maschili in lunghi amenti penduli, quelli femminili hanno il perianzio concresciuto con l'ovario, hanno aspetto gemmiforme da cui fuoriescono evidenti stimmi rossi, piccoli.
Fioritura:
Il nocciolo è uno dei primi alberi a fiorire; il periodo di pollinazione può iniziare già a fine dicembre e si protrae fino all'inizio di marzo.

Graminacee:
Diffusione:
La famiglia è cosmopolita e in Italia è presente ovunque.
Descrizione:
La famiglia delle graminacee comprende piane erbacee, annue o perenni, con fusto cilindrico, articolato e vuoto negli internodi, foglie semplici, alterne, provviste di una guaina che abbraccia il fusto.
I fiori sono riuniti in spighe o pannocchie terminali.
Ciascun gruppo di fiori è costituito da due bratteole per ciascun fiore, dette glumette, all'interno delle quali si trovano l'ovario e gli stami.
Il frutto è una cariosside con seme saldato alla parete dell'ovario. Alla famiglia delle graminacee appartengono generi di piante spontanee e coltivate (cereali), talvolta infestanti.
Fioritura:
Considerando il grande numero di specie la fioritura della famiglia è distribuita per un periodo molto lungo che va dalla fine di febbraio a ottobre.

Parietaria:
Diffusione:
Comunemente presente nell'Europa centroccidentale, normalmente non supera la quota del 1200 metri di altezza.
Descrizione:
Alla famiglia appartengono due generi, Parietaria e Urtica.
Il genere Parietaria è quello di maggior interesse allergologico, in particolare con la specie P. diffusa M. et K. Sono dette piante ruderali perchè crescono ai margini delle strade, accanto alle abitazioni e nei luoghi incolti e secchi, o sulle mura. Spesso richiedono terreni carichi di azoto.
Si trovano sottoforma di arbusti erbacei, ramificati, altri fino a 50cm. Le foglie sono sempli alterne, intere ovate ad apice acuto. I fiori, piccolissimi, presentano stami ripiegati all'interno che con il disseccamento si aprono verso l'esterno liberando il polline.
I frutti sono piccoli acheni.
Fioritura:
A seconda della latitudine la fioritura può protarsi anche durante l'intero anno.

Ulivo:
Diffusione:
La sua distribuzione si identifica con il bacino del mediterraneo. E' una specie ad accrescimento lento, che predilige terreni calcarei e vulcanici.
Un soggetto allergico all'ulivo può presentare sintomatologia quando è presente in aria polline di altre Oleacee quali frassino, ligustro, gelsomino.
Descrizione:
Albero sempreverde, molto longevo, presenta tronco irregolare, contorto, soprattutto in esemplari vecchi, corteccia grigio chiara. Le foglie sono semplici, lancelolate, opposte, con una consistenza coriacea. Hanno un colore verde chiaro nella pagina superiore e argenteo nella pagina inferiore.
I fiori sono bianchi e poco appariscenti, ermafroditi e raccolti in racemi ascellari.
Il frutto è una drupa ovale e oleosa, dapprima verde, nera a maturità. Le forme selvatiche hanno rami spinescenti, foglie più brevi e frutti più piccoli e meno polposi.
Fioritura:
Da metà aprile a fine maggio.

Muffe- Alternaria:
L'Alternaria è un fungo che si manifesta sotto forma di linee, punti o circoli scuri il cui diametro può raggiungere le dimensioni di un piatto. La sua presenza viene rilevata di sovente nei bagni. Cresce naturalmente all'aria aperta su materiale vegetale, ma anche in ambienti chiusi su legno, guarnizioni in silicone, pareti o tessuti, ovvero nei luoghi in cui si accumula l'acqua di condensa o di altre fonti di umidità. Nell'Europa centrale, la stagione dell'Alternaria inizia a metà giugno, raggiunge il picco a luglio o agosto e termina a settembre o ottobre con la dispersione di spore per via aerea. Spesso le piogge estive rilasciano una grande quantità di spore, e la convezione termica ne favorisce la diffusione per via aerea una volta che il suolo si è asciugato. Le spore di Alternaria presentano una potenza allergenica da moderata ad elevata.
Muffe- Cladosporium:
Il Cladosporium è una muffa diffusa in tutto il mondo. All'aperto si ritrova spesso su materiale organico in decomposizione quali piante e legno, mentre negli ambienti interni si può trovare su pareti e oggetti danneggiati dall'acqua e, addirittura, sui cibi conservati in frigorifero. Le spore di Cladosporium sono di dimensioni ridotte, hanno una caratteristica superficie rugosa e un colore che va da marrone chiaro a marrone scuro. Analogamente all'Alternaria, la sua stagione inizia a metà giugno, raggiunge il picco a luglio-agosto e termina a settembre o ottobre con la dispersione di spore per via aerea. Spesso le piogge estive rilasciano una grande quantità di spore, e la convezione termica ne favorisce la diffusione per via aerea una volta che il suolo si è asciugato. Le spore di Cladosporium presentano una potenza allergenica moderata.

Acari della polvere:
Le reazioni allergiche agli acari della polvere domestica sono tra le più diffuse. I sintomi classici di questa allergia, nota talvolta come allergia alla polvere, includono naso che cola, prurito o ostruzione nasale, prurito o gonfiore agli occhi e tosse, soprattutto la mattina al risveglio. In realtà l'allergene è costituito non tanto dagli acari, bensì dalle loro feci, le quali, più piccole dei normali grani di polline, sono rivestite da un sottile strato protettivo che con il tempo si decompone rilasciando delle minuscole particelle allergeniche.

Animali domestici:
Gli animali domestici perdono costantemente peli e cellule cutanee, in particolare durante la toelettatura. Questa forfora si deposita su biancheria da letto, moquette e mobili e si disperde nell'aria quando si verificano degli spostamenti. Toccare e accarezzare gatti e altri animali può a sua volta scatenare reazioni allergiche, quali irritazioni cutanee ed eruzioni accompagnate da prurito.

Guida alle allergie
Ulteriori informazioni sui 4 tipi di allergia più comuni e su come gestirli.

Vuoi combattere l'allergia?
Puoi scoprire un trattamento antiallergico con le compresse di Reactine, a base di cetirizina e pseudoefedrina.
